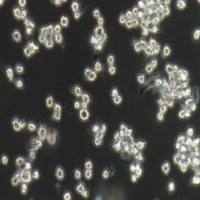
NR8383大鼠肺泡巨噬细胞（提供种属鉴定）

相关产品推荐更多 >
万千商家帮你免费找货
0 人在求购买到急需产品
- 详细信息
- 文献和实验
- 技术资料
- 品系:
横纹肌肉瘤
- 细胞类型:
横纹肌肉瘤细胞
- 肿瘤类型:
人横纹肌肉瘤细胞
- 供应商:
优利科(上海)生命科学有限公司
- 库存:
3
- 英文名:
Human Rhabdomyosarcoma Cells ,A204
- 生长状态:
贴壁生长
- 年限:
永久
- 运输方式:
快递形式
- 器官来源:
人横纹肌肉瘤细胞
- 是否是肿瘤细胞:
是
- 细胞形态:
上皮细胞样,贴壁生长
- 免疫类型:
/
- 物种来源:
人横纹肌肉瘤细胞
- 相关疾病:
横纹肌肉瘤
- 组织来源:
横纹肌肉
- 规格:
1*10^6
A-204人横纹肌肉瘤细胞(提供STR鉴定报告)细胞介绍
Human Rhabdomyosarcoma Cells ,A204
A-204人横纹肌肉瘤细胞(提供STR鉴定报告)细胞特性
1) 来源:横纹肌肉瘤
2) 形态:上皮细胞样,贴壁生长
3) 含量:>1x10^6 细胞数
4) 规格:T25瓶或者1mL冻存管包装
5)用途:仅供科研使用。

A-204人横纹肌肉瘤细胞(提供STR鉴定报告)运输和保存
干冰运输及复苏好存活细胞
(1)1mL冻存管包装干冰运输,收到后-80度冰箱保存过夜后转入液氮或直接复苏,若发现干冰已挥发干净、冻存管瓶盖脱落、破损及细胞有污染,请立即与我们联系。
(2)T25瓶复苏的存活细胞常温发货,收到后按照细胞接收后的处理方法操作。

A-204人横纹肌肉瘤细胞(提供STR鉴定报告)培养基及培养冻存条件准备:
1) 准备McCoy`s 5A培养基;优质胎牛血清,10%;双抗,1%。
2) 培养条件: 气相:空气,95%;二氧化碳,5%。 温度:37摄氏度,培养箱湿度为70%-80%。
3) 冻存液:90%血清,10%DMSO,现用现配。

A-204人横纹肌肉瘤细胞(提供STR鉴定报告)接收后的处理
1)收到细胞后,75%酒精消毒瓶壁将T25瓶置于37℃培养箱放置约2-3h,若发现培养瓶破损、有液溢出及细胞有污染,请拍照后及时联系我们。
2)请在4或5X显微镜下确认细胞状态,同时给刚收到的细胞拍照(10×,20×)各2-3张以及培养瓶外观照片一张留存,作为售后时收到时细胞状态的依据。
3)贴壁细胞:细胞在37℃培养箱中放置2-3h,显微镜下观察细胞的生长和贴壁情况,有些贴壁细胞在快递运送过程中会因振动脱落和脱落后成团的情况。若镜下观察细胞的生长密度若在60%以下,可去除培养瓶中灌液培养基(若有未贴壁的细胞需要离心回收,重悬打入到原培养瓶中),加入新配制的完全培养基6-8mL,放到细胞培养箱中继续培养。若细胞生长密度达70%-80%以上,可以对细胞进行传代处理。传代过程中,若因运输振动脱落的细胞需要离心回收。
4)备注:运输用的培养基(灌液培养基)不能再用来培养细胞,请换用按照说明书细胞培养条件新配制的完全培养基来培养细胞。 收到细胞后第一次传代建议T25培养瓶1:2传代 。

A-204人横纹肌肉瘤细胞(提供STR鉴定报告)相关产品:
| 人膀胱癌细胞 | 5637 |
| 人甲状腺癌细胞8305C(未分化) | 8305C |
| 人骨肉瘤细胞 | 143B |
| 人前列腺癌细胞 | 22RV1 |
| 人胚肾细胞 | 293T |
| 人高转移鼻咽癌细胞系 | 5-8F |
| 人肾细胞腺癌细胞 | 769-P |
| 人肾透明细胞腺癌细胞 | 786-O[786-0] |
| 人高转移肺癌细胞 | 95-D |
| 人胶质母细胞瘤细胞 | A172 |
风险提示:丁香通仅作为第三方平台,为商家信息发布提供平台空间。用户咨询产品时请注意保护个人信息及财产安全,合理判断,谨慎选购商品,商家和用户对交易行为负责。对于医疗器械类产品,请先查证核实企业经营资质和医疗器械产品注册证情况。
文献和实验1) 细胞消化液的配制及存储:我采用的是0.25%Trypsin+0.05%EDTA的消化液,BUFFER采用的是D-Hank's液。配完后分装成4-5ml/tube,于-20度冰箱中储存。2) 消化前的处理:当细胞生长至亚融和状态需要传代时,提前半小时将配好的消化液放在细胞培养孵箱中预热,同时将配好的高压无菌的D-Hank's液也进行预热。3) 消化细胞:将预热的D-Hank's液洗细胞2次,2ml/25cm2,然后再加入预热的消化液,作用3-5min,并反复振荡,镜下观察。当细胞被消化
短串联重复序列(short tandem repeat,STR),又称为微卫星DNA ,重复单位为2-6bp,重复次数10~60多次,在DNA复制过程中的滑动、复制、修复过程中滑动链与互补链的碱基错配,从而导致一个或几个重复单位的缺失或插入,形成STR的多态性,主要应用于遗传连锁图谱分析、家系鉴定、身份认证等领域,同时也是鉴定细胞株被错误识别和交叉污染的主要工具。细胞株被错误识别及交叉污染的现象还是比较普遍的,虽然科研工作者使用各种各样的传统方法来鉴定细胞,但细胞交叉污染的问题却有增无减
的芯片种类,费用在1500-3000RMB每样本左右。 谢谢xcq1127战友,我查了我这个基因,近的STR好像不多,只能选较近的上下游的两个了,然后同时再选SNP,你看行么?芯片的话还是适用于较长片段LOH把? 本文由丁香园论坛提供,想了解更多有用的、有意思的前沿资讯以及酷炫的实验方法的你,都可以成为师兄的好伙伴 师兄微信号:shixiongcoming